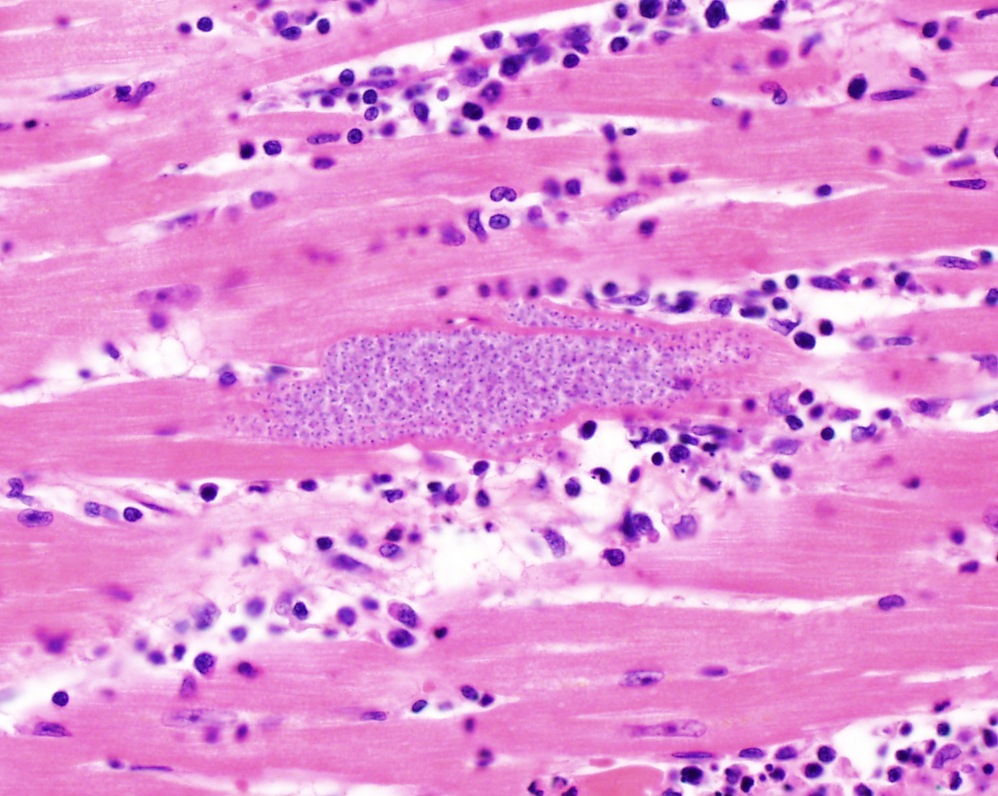
ParasiteGal's tweet image. Here’s a special Valentine’s day case on matters of the heart – inspired by @MeredithKHerman: parasitewonders.blogspot.com/2023/02/case-o…  Answer later this week. #mayopath #pathology #IDPath #CrittersOnTwitter #PathBugs
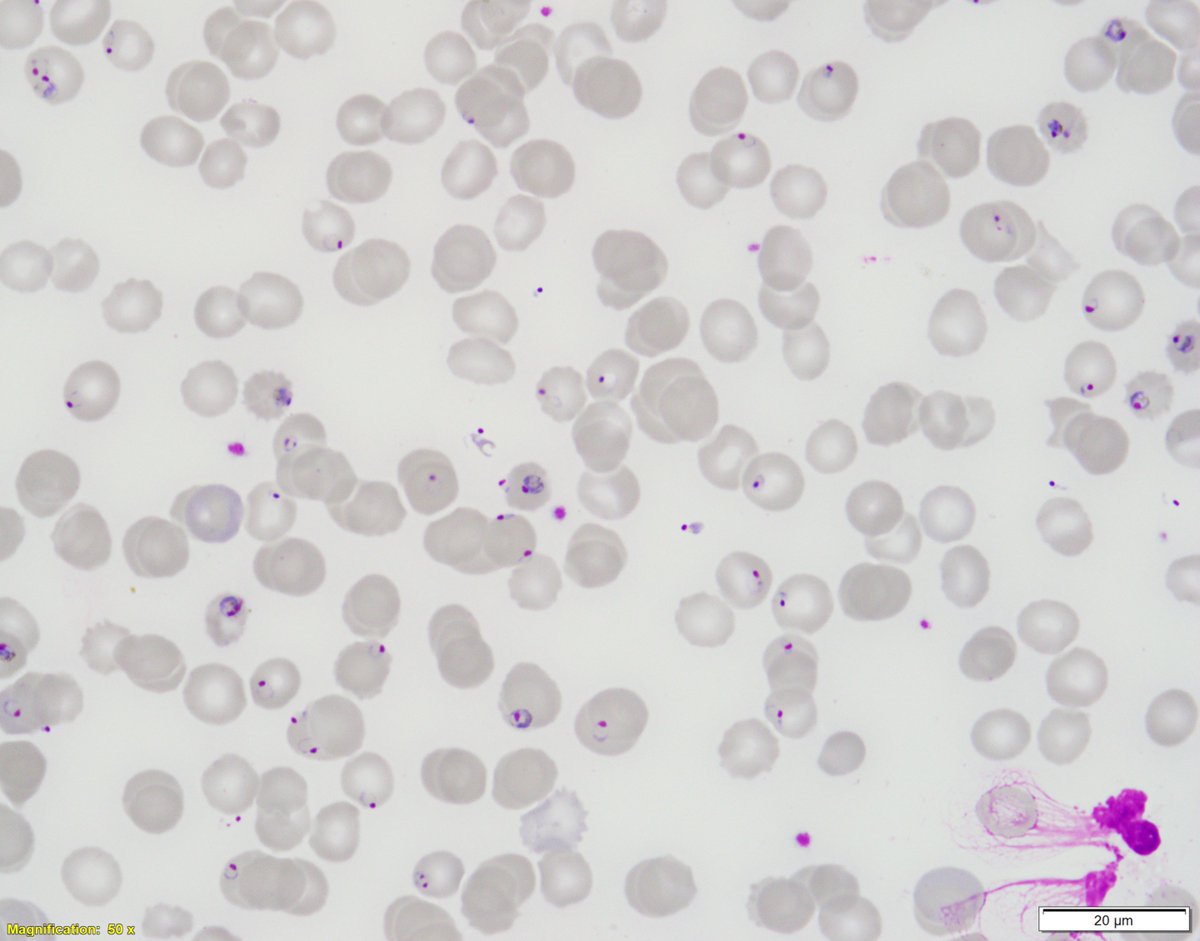
ParasiteGal's tweet image. This week’s impressive case is donated by Dr. Ryan Relich: parasitewonders.blogspot.com/2023/02/case-o… Diagnosis?  Answer later this week! #mayopath #pathology #IDPath #CrittersOnTwitter #PathBugs
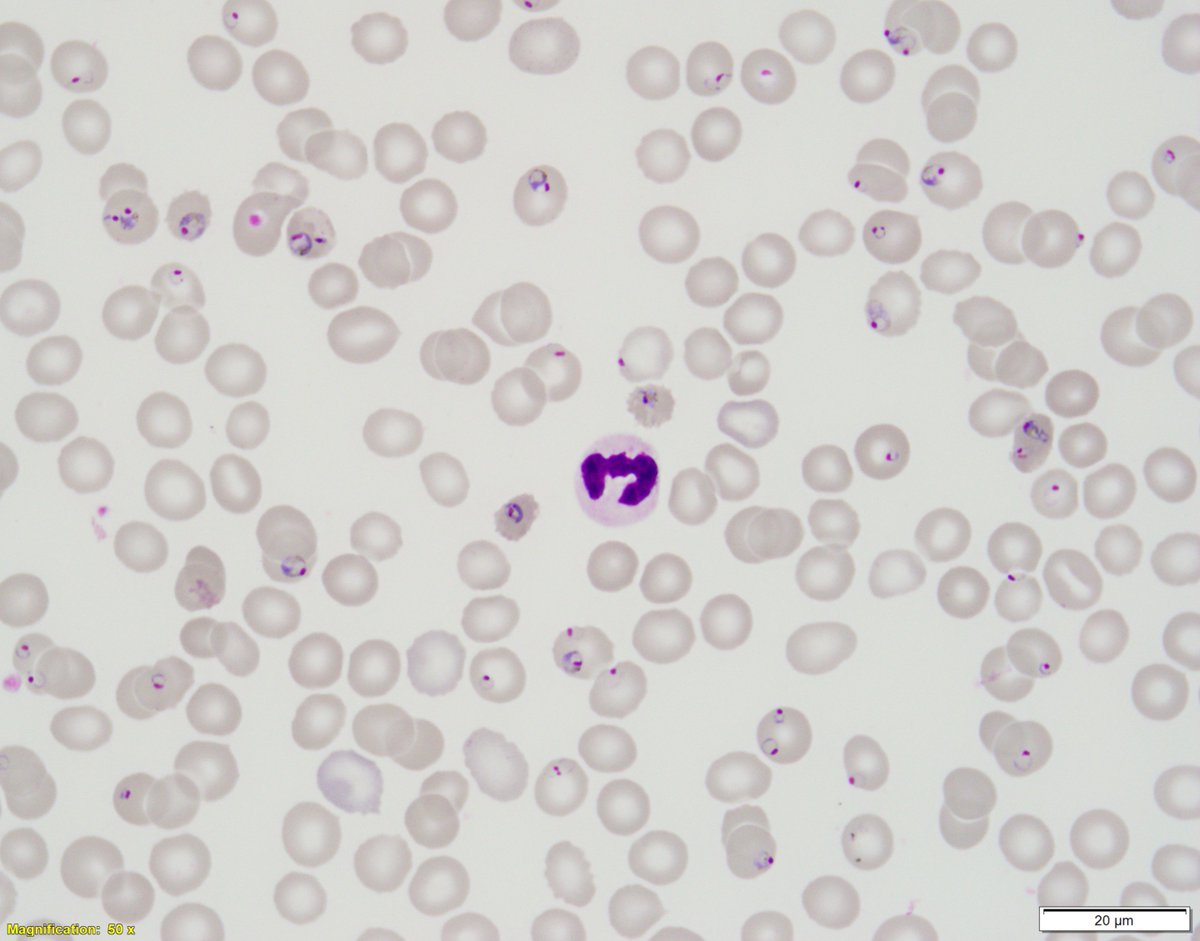
ParasiteGal's tweet image. This week’s impressive case is donated by Dr. Ryan Relich: parasitewonders.blogspot.com/2023/02/case-o… Diagnosis?  Answer later this week! #mayopath #pathology #IDPath #CrittersOnTwitter #PathBugs

#idpath search results
#IDpath Sequelae of a hail storm in Massachusetts. Made be think of Cryptococcus. I may need to get out more.


When you tell your attending the AFB stain is negative and they see bugs on the first field of view #pathology #pathtwitter #idpath

This is awesome! #IDPath
Adult male. Nasal scrapings. #PathX #PathTwitter #ENTPath #HeadandNeckpath #IDpath #Pathbugs #CrittersonX #Critternsontwitter




surgical&medicine interns outside micro lab🧑🔬window wondering if cultures (drawn 1hr ago) are final yet🧫 #clinpath #IDpath
20s F with evolving nodules mostly on the extremities of several months duration. Organisms were seen with some difficulty with special stains and retrospectively with H&E. Molecular identification by PCR: Blastomyces spp. #dermpath #pathology #IDpath




Coccidioides immitis. #pathbugs #crittersonX #idpath #lungpath #thoracicpath
Lung resection specimen revealing a mycetoma filled with what organism? Answer: buff.ly/3ZMvLjG #IDTwitter #PathTwitter #MedTwitter #PathArt

From our newly released series 5 fascicle: Pathology of Non-Helminth Infectious Disease (arppress.org/books/book/65/): T. pallidum infections are characterized by endothelial cell swelling/proliferation and a plasma-cell rich perivascular inflammatory infiltrate. #IDpath

57. PGY1s, learn this one slide and you will be good to go for 4 major fungal infections. GOLD for boards!! x.com/Janiranavarro/…
me (texting resident): Dx on TURBT case X level A1-2? res: 🤨 me: stay lowpower so you don't fly over the focus res: 😳 me: it's okay if you're not sure, just wing the Dx res:😬 me: no worries, don't let it bug you res:😑 #dadjokes when #GUpath meets #IDpath

17M, Reflux sx refractory to PPI therapy. EGD showed nodular antral mucosa. Random stomach biopsy with chronic gastritis, lymphoid aggregates #pedipath #gipath #idpath



Neurocysticercosis! When you see it once, you never forget #pathology #pathresidents #neuropath #PathTwitter 👀 🔬


#GIPath #IDPath @BrownPathology A 60 year old man presents with perforated diverticulitis - with a curious finding in the serosal inflammation: Poll in reply.



A few reactive and plasmacytoid lymphocytes. History of fever, a couple dengue positive. #hemepath #PathTwitter #IDpath

More from the non-helminth infectious diseases fascicle (arppress.org/books/book/65): Leprosy, caused by Mycobacterium leprae/Mycobacterium lepromatosis, has diverse histologic findings; tuberculoid leprosy has perineural lymphocyte and epithelioid histiocyte infiltrates. #IDpath

Liver biopsy with Capillariasis infection in an infant #pathology #pedipath
57. PGY1s, learn this one slide and you will be good to go for 4 major fungal infections. GOLD for boards!! x.com/Janiranavarro/…
fab #IDpath case! when I used to also🔬#GIpath I’d tell trainees: TAKE HOME POINT: don't be afraid to dig in the trash! (don't ignore ulcer debris)
Indeed this is amebic colitis! Uncommon in western world (h/o travel is important). Characteristic flask shaped ulcers, amebic trophozoites often with ingested RBCs. #pathboards
Liver biopsy with Capillariasis infection in an infant #pathology #pedipath
#GIPath #IDPath @BrownPathology A 60 year old man presents with perforated diverticulitis - with a curious finding in the serosal inflammation: Poll in reply.



Incidental finding in penectomy specimen, in the necrotic areas. Features of squamous cell carcinoma seen in preserved focus. Thinking of dead worm. Any definite diagnosis? Please opine. #PathTwitter @ParasiteGal @yro854 @Histopatolomon @DrGeeONE #IDpath #crittersontwitter




❌Lactating Adenoma Proliferation of glands showing secretory/lactational change Lacks granulomas/significant inflammation unless ruptured. #BreastPath #IDPath #Pathology #PathTwitter



\IDPATH-LINEスタンプ販売開始しました!/ 早速Chat GPTの画像生成+CANVA(画像編集)を使い、LINEスタンプを作成しました。 実用性はないです。 👉 購入はこちら store.line.me/stickershop/pr… #LINEスタンプ販売中 #実用性ゼロ #IDPATH #chatgpt画像生成 #canva #chatgpt4o
「夢を追いかける瞬間は、いつもこんなものさ。 落ちるかもしれない不安と、無音の絶望に襲われる」 -Roulette_Jump-part2ショート動画- #IDPATH #ストーリー #AI音楽 ※このBGMはご自身のSNS投稿などで自由に使用OK! ダウンロードはこちら▼ idpath-ai.site/works/
🚗夢を追う瞬間、世界は音を失う── 命ごとBETして飛んだ景色、見たことあるか? 「Roulette_Jumpショート動画公開」 感想くれたら飛んで喜びます。 #IDPATH #物語音楽 #AI音楽 ※このBGMはご自身のSNS投稿などで自由に使用OK! ダウンロードはこちら▼ idpath-ai.site/works/
深海にいた私は――出会えたんだ。 「希望」に。 だから今、私は走り出す。光の道を。 #IDPATH #作業用BGM #物語のある音楽 ぜひ、聴いて~! ※このBGMはご自身のSNS投稿などで自由に使用OK! ダウンロードはこちらから▼ idpath-ai.site
そんな切ない想いが、 ぎゅっと詰まった一曲です。 その強がりの裏に、 隠した本音…ぜひ、感じ取って… あ、やば、ソフィーだ。逃げろー!! -ソフィー- 「ちょっとサンゴ!勝手に何やってるの//」 #IDPATH #ソフィー #ツンデレ #UnspokenFeelings #オリジナル曲
強がるほど、心は泣いてた。 「好き」なんて言葉に意味はないと思ってた。 最後まで聴いたからって、 勘違いしないで。 ……これは、私の弱さじゃない。 ただの、歌よ。 #IDPATH #ソフィー #ツンデレ #UnspokenFeelings #オリジナル曲
心理的安全性の物語版はインスタで公開しているので、ぜひ見てください。 サイコロジカルゲーム↓ instagram.com/p/DHFCeSDTBQP/ #心理的安全性 #職場環境 #IDPATH
「公開前動画」 絵悟悠真です。IDPATHのサイトの紹介動画を作りました。 公開は2025年3/15の土曜日、だいたい夜19時頃に公開。 YOUTUBEで見れますので、見ていただけると幸いです。 youtu.be/VT0DhNVWCr0 #クリエイター #IDPATH #新時代の幕開け

youtube.com
YouTube
IDPATH-サイト紹介-フルバージョン
こんにちは。現在サイト作成中です。 🎬【革命の入り口 – IDPATH】 画像はサイトトップ画像です。 これはただのサイトではない。 土曜日の夜、全てを公開。 サイトでは 💥 AI × 収益化 💥 目標達成 × 自己実現 💥 狂ったコンテンツ × エンタメ を提供。 #IDPATH #クリエイター革命 #新時代の幕開け

初めまして。私は オルフェ。 この曲の題名はまだない。 あなたが感じたままの世界を、この音楽とともに描いてみて。 では、音の波の中で、また逢いましょう。 🎧 フルバージョンはYOUTUBEで🎧 👉 [youtu.be/FiHdp3QDg4k] #オルフェ #idpath #新曲配信 #音楽の旅
an early #GUpath #IDpath holiday🎁for everyone! prostate bx: granulomatous prostatitis secondary to Coccidioides (patient had hx)



Thank you all for your response. This was Condyloma acuminata. 🔬1️⃣Hyperplastic papillary exophytic squamous epithelium 2️⃣Marked acanthosis 3️⃣Parakeratosis 4️⃣Fibrovascular core 5️⃣Koilocytosis (irregular nuclei, binucleate, perinuclear halo) #gipath #IDpath


Continuing on the muscle parasite theme… What is this one, and how does it differ from my last 2 cases? parasitewonders.blogspot.com/2023/02/case-o… Answer later this week. #mayopath #pathology #IDPath #CrittersOnTwitter #PathBugs


Here’s a special Valentine’s day case on matters of the heart – inspired by @MeredithKHerman: parasitewonders.blogspot.com/2023/02/case-o… Answer later this week. #mayopath #pathology #IDPath #CrittersOnTwitter #PathBugs

When you tell your attending the AFB stain is negative and they see bugs on the first field of view #pathology #pathtwitter #idpath

🥚🐰Happy Easter all! ✏️Short case this week as it holidays. ⚕️Adult, small bowel and stomach #GIpath #IDpath #Pathtwitter #pathresidents




me (texting resident): Dx on TURBT case X level A1-2? res: 🤨 me: stay lowpower so you don't fly over the focus res: 😳 me: it's okay if you're not sure, just wing the Dx res:😬 me: no worries, don't let it bug you res:😑 #dadjokes when #GUpath meets #IDpath

numerous #pathtweets images avail for molluscum contagiosum... however, adding this🔬 from breast skin bx😲 #IDpath #dermpath




This week’s impressive case is donated by Dr. Ryan Relich: parasitewonders.blogspot.com/2023/02/case-o… Diagnosis? Answer later this week! #mayopath #pathology #IDPath #CrittersOnTwitter #PathBugs

20s F with evolving nodules mostly on the extremities of several months duration. Organisms were seen with some difficulty with special stains and retrospectively with H&E. Molecular identification by PCR: Blastomyces spp. #dermpath #pathology #IDpath




Perigastric lymph node showing loads of Mycobacteria (MAIC) in a immunocompromised (HIV positive) patient. Fite-Faraco stain #CrittersOnTwitter #CrittersOnX #IDpath #Pathology @SumantaDas_7 @kriyer68 @Praachy27 @saray_gonul @pepeheffernan @ariella8 @TjLimMD @vi_monappa




#IDpath Sequelae of a hail storm in Massachusetts. Made be think of Cryptococcus. I may need to get out more.


From the infectious disease fascicle (arppress.org/books/book/65): Toxoplasmosis is caused by an obligate intracellular protozoan and is one of the most prevalent human infections worldwide (25-75%, region dependent). Many organs can be affected, including the brain. #IDpath

From the archives – 3 different preps of the same parasite in vaginal secretions: parasitewonders.blogspot.com/2023/03/case-o… (conventional smear, ThinPrep, and Giemsa Cytospin) Which one is your favorite? #mayopath #pathology #IDPath #CrittersOnTwitter #PathBugs



こんにちは。現在サイト作成中です。 🎬【革命の入り口 – IDPATH】 画像はサイトトップ画像です。 これはただのサイトではない。 土曜日の夜、全てを公開。 サイトでは 💥 AI × 収益化 💥 目標達成 × 自己実現 💥 狂ったコンテンツ × エンタメ を提供。 #IDPATH #クリエイター革命 #新時代の幕開け

This week’s classic case was donated by SStacyGBeal and colleagues – found on a liver biopsy: parasitewonders.blogspot.com/2023/03/case-o… Answer later this week! #mayopath #pathology #IDPath #CrittersOnTwitter #PathBugs


Friday #dermpath special. 😆🔬 Too obvious on low power? Negatron! Go higher not to miss this diagnosis. Chromoblastomycosis #pathology #IDpath 🍄🐛



The #Parasite Case of the Week is now up: worm in the blood! Diagnosis? parasitewonders.blogspot.com/2023/05/case-o… #mayopath#pathology #IDPath #CrittersOnTwitter #PathBugs

A few reactive and plasmacytoid lymphocytes. History of fever, a couple dengue positive. #hemepath #PathTwitter #IDpath

Something went wrong.
Something went wrong.
United States Trends
- 1. Melania N/A
- 2. Alex Jones N/A
- 3. Demar N/A
- 4. North Dakota N/A
- 5. Sandy Hook N/A
- 6. Hunter Biden N/A
- 7. Afrika Bambaataa N/A
- 8. British Nationals N/A
- 9. #FrozenFour N/A
- 10. #LightningStrikes N/A
- 11. Bill and Ted N/A
- 12. #ENHYPEN_Is_Forever_sevEN N/A
- 13. #OnWisconsin N/A
- 14. Hassan Campbell N/A
- 15. Luis Robert N/A
- 16. FLOTUS N/A
- 17. Larry Devoe N/A
- 18. Brigitte Macron N/A
- 19. Badgers N/A
- 20. Wachovia N/A



















































